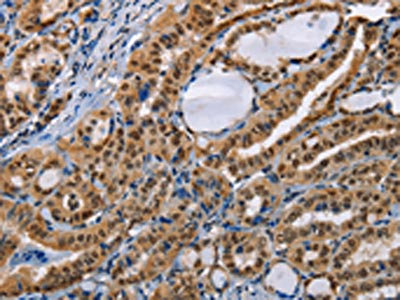

-
中文名稱:BAG1兔多克隆抗體
-
貨號:CSB-PA045995
-
規格:¥1100
-
圖片:
-
The image on the left is immunohistochemistry of paraffin-embedded Human thyroid cancer tissue using CSB-PA045995(BAG1 Antibody) at dilution 1/40, on the right is treated with fusion protein. (Original magnification: ×200)
-
Gel: 8%SDS-PAGE, Lysate: 50 μg, Lane 1-3: Hela cells, K562 cells, Raji cells, Primary antibody: CSB-PA045995(BAG1 Antibody) at dilution 1/750, Secondary antibody: Goat anti rabbit IgG at 1/8000 dilution, Exposure time: 2 seconds
-
-
其他:
產品詳情
-
Uniprot No.:
-
基因名:
-
別名:Bag 1 antibody; BAG family molecular chaperone regulator 1 antibody; BAG-1 antibody; BAG1 antibody; BAG1_HUMAN antibody; BCL 2 Associated Athanogene 1 antibody; BCL 2 associated athanogene antibody; BCL 2 binding athanogene 1 antibody; Bcl-2-associated athanogene 1 antibody; BCL2 associated athanogene 1 antibody; BCL2 associated athanogene antibody; Glucocorticoid receptor-associated protein RAP46 antibody; HAP1 antibody; Haptoglobin antibody; RAP 46 antibody; RAP46 antibody
-
宿主:Rabbit
-
反應種屬:Human
-
免疫原:Fusion protein of Human BAG1
-
免疫原種屬:Homo sapiens (Human)
-
標記方式:Non-conjugated
-
抗體亞型:IgG
-
純化方式:Antigen affinity purification
-
濃度:It differs from different batches. Please contact us to confirm it.
-
保存緩沖液:-20°C, pH7.4 PBS, 0.05% NaN3, 40% Glycerol
-
產品提供形式:Liquid
-
應用范圍:ELISA,WB,IHC
-
推薦稀釋比:
Application Recommended Dilution ELISA 1:2000-1:5000 WB 1:500-1:2000 IHC 1:50-1:200 -
Protocols:
-
儲存條件:Upon receipt, store at -20°C or -80°C. Avoid repeated freeze.
-
貨期:Basically, we can dispatch the products out in 1-3 working days after receiving your orders. Delivery time maybe differs from different purchasing way or location, please kindly consult your local distributors for specific delivery time.
-
用途:For Research Use Only. Not for use in diagnostic or therapeutic procedures.
相關產品
靶點詳情
-
功能:Co-chaperone for HSP70 and HSC70 chaperone proteins. Acts as a nucleotide-exchange factor (NEF) promoting the release of ADP from the HSP70 and HSC70 proteins thereby triggering client/substrate protein release. Nucleotide release is mediated via its binding to the nucleotide-binding domain (NBD) of HSPA8/HSC70 where as the substrate release is mediated via its binding to the substrate-binding domain (SBD) of HSPA8/HSC70. Inhibits the pro-apoptotic function of PPP1R15A, and has anti-apoptotic activity. Markedly increases the anti-cell death function of BCL2 induced by various stimuli.
-
基因功能參考文獻:
- Here the authors show that the AF-1 domain of AR is bound by the cochaperone Bag-1L. PMID: 28826504
- Over expression of BAG-1 may be a biomarker for cisplatin resistance in patients with primary or recurrent head and neck squamous cell carcinoma. PMID: 28877725
- Increased BAG-1 by PD-L1 confers resistance to tyrosine kinase inhibitor in non-small cell lung cancer via persistent activation of ERK signaling. PMID: 28892778
- BAG-4/SODD, HSP70, and HSP90 are potential prognostic markers in node-negative breast carcinoma that merit further research. PMID: 27038683
- interaction with Bag1 then shifts hERG degradation to the membrane-anchored E3 ligase TRC8 and its E2-conjugating enzyme Ube2g2, as determined by siRNA screening PMID: 27998983
- These results suggest that Bag1 and Bag3 control the stability of the Hsc70-client complex using at least two distinct protein-protein contacts, providing a previously under-appreciated layer of molecular regulation in the human Hsc70 system. PMID: 27474739
- Taken together, these data indicate that Bag-1 up-regulation is required to maintain apoptosis resistance in human cytomegalovirus-infected cells. PMID: 26087710
- the combined effects of BAG-1 and XPD polymorphisms on chemotherapy sensitivity and survival in patients with advanced non-small-cell lung cancer, which might be the important predictive markers for platinum-based chemotherapy efficacy. PMID: 26124006
- Bag-1 indirectly affects cell survival through c-Myc activated signalling that causes elevation of ornithine decarboxylase levels, leading to an increase of the polyamine content. PMID: 26178413
- Overexpression of miR-138 inhibited cell proliferation by directly suppressing the expression of Bag-1. PMID: 25962180
- The expression of BAG-1 was upregulated in chronic non-eosinophilic rhinosinusitis. PMID: 24830325
- BAG-1 expression was high in esophageal carcinoma tissues compared to normal esophagus. After Eca109 cells were transfected with BAG-1-siRNA, the proliferation and invasive capabilities of the cells were decreased while the apoptosis rate was enhanced. PMID: 25069471
- BAG-1M mediates Hsp70 inhibition downstream of NF-kappaB. PMID: 24876225
- Forced Bag-1L expression prevented Cisplatin-induced apoptosis. PMID: 24969872
- distinct isoforms of BAG-1 had different anti-apoptotic ability in breast cancer cells treated with the 4-OH TAM. PMID: 24557447
- BAG-1M and HspBP1 had differential impacts on the dynamic composition of steroid receptor folding complexes PMID: 24454860
- GARRPR in Bag-1L as a novel BF-3 regulatory sequence important for fine-tuning the activity of the AR PMID: 24523409
- The results present that the constructed shRNA plasmids significantly inhibited the expression of mRNA and protein of Lo Vo cell BAG-1, and can maintain the effect for a long term PMID: 24061638
- Bag1 is expressed at a higher level in functioning- compared to non-functioning pituitary adenomas. PMID: 23023342
- we measured the binding of human Hsp72 (HSPA1A) to BAG1, BAG2, BAG3, and the unrelated NEF Hsp105. These studies revealed a clear hierarchy of affinities: BAG3 > BAG1 > Hsp105 >> BAG2. PMID: 24318877
- BAG1 expression provides significant prognostic information when added to the classical clinicopathological parameters and IHC4, particularly in node-positive patients. PMID: 23852223
- Chlamydia up-regulate Bag-1 via the MAPK/ERK survival pathway. PMID: 23708800
- BAG-1 suppresses expression of the key regulatory cytokine transforming growth factor beta (TGF-beta1) in colorectal tumour cells. PMID: 23108401
- Results for the first time indicated that BAG-1 was dysregulated in HCC and suppression of BAG-1 expression which resulted in inhibiting of NF-kappaB signaling might be developed into a new strategy in HCC therapy. PMID: 23553841
- we identified Caspase 3, BAG1 and BAG3 as key targets of ERalpha in neuronal cells that may play a role in ERalpha-mediated neuroprotection. PMID: 23271418
- BAG-1 expression in meningioma depends upon WHO pathologic classification and is decreased in higher tumor classification PMID: 23322525
- The expression of anti-apoptosis gene Bcl-2 associated anthanogen-1 (Bag-1), has been associated with outcome in several cancer types, however its prognostic role in pancreatic cancer is unknown. PMID: 22939115
- Studied expression of BAG-1 and PARP-1 in LSILs, HSILs and SCCs. Research suggests BAG-1 expression could contribute to the differentiation between LSIL and HSIL/SCC whereas PARP-1 could be useful to the differentiation between HSIL HPV-related and SCC. PMID: 22454210
- A peptide sequence derived from the cochaperone Bag-1 modulates the unfolded protein response and induces prostate cancer cell death.( PMID: 23049684
- BAG-1 is highly expressed in the majority of colorectal tumours, targeting the Rb-BAG-1 complex to promote apoptosis. PMID: 23059827
- ERCC1 and BAG-1 are determinants of survival after surgical treatment of NSCLC, and its mRNA expression in tumor tissues could be used to predict the prognosis of NSCLC treated by platinum. PMID: 22439756
- Expression of BAG-1 was closely associated with the sensitivity to platinum-based chemotherapeutics in non-small cell lung carcinoma patients. PMID: 22179630
- Decreased allelic frequency of the BAG-1 rs706118 SNP was observed in patients with frontotemporal lobar degeneration as compared with controls, whereas allelic frequency of the SNP in patients with Alzheimer's disease was similar to controls. PMID: 21157029
- BAG1 protein was found highly expressed in children with acute myeloid leukemia PMID: 22016818
- BAG1 induction is essential for protecting cells from MYC-induced apoptosis. PMID: 21986497
- Bag-1 protein was found to be overexpressed in colorectal cancer. PMID: 21809033
- silencing of the BAG-1 gene resulted in changes in expression of apoptosis-related genes and sensitized A549 and L9981 cells to cisplatin-induced apoptosis. PMID: 20404511
- Overexpression of Bag-1 in poorly differentiated SCC may confer both enhanced tumor cell growth and apoptosis resistance. Bag-1 may contribute to the resistance of more advanced epidermal SCC to chemotherapy. PMID: 21522149
- Overexpression of BAG-1 and p53 plays an important role in the process laryngeal squamous cell carcinoma development. PMID: 16398049
- These data suggest that IGFBP3 and BAG1 may be key markers of radiosensitivity that enhance the susceptibility of squamous cell esophageal cancer to radiotherapy PMID: 21195059
- Bag1 induced binding of immature BCR-ABL to proteasome. PMID: 20675402
- BAG-1 nuclear isomorph appeared more frequently in grade 2 endometrial tumors than in grade 1 and 3 tumors, and the cytoplasmatic isomorph was expressed more strongly than the nuclear one. PMID: 21036726
- Bag-1 proteins function as regulators of the action of selective transcription factors. PMID: 20858459
- Expression of Bag-1 in colon cancer was closely correlated with pathologic grade, distance metastasis, Duke stage, and prognosis, but it had no effect on the pathologic type, tumor diameter, depth of invasion, and lymphoid node metastasis of the cancer. PMID: 20409521
- aberrant expression and subcellular distribution of Bag-1 might play an important role in the malignant transformation of gastric epithelial cells and should be considered as a biomarker for gastric carcinogenesis, subsequent progression, and prognosis. PMID: 20096920
- Wild-type DJ-1 possesses chaperone activity, which is abolished by the L166P mutation which is reversed by the expression of the cochaperone BAG1. PMID: 20156966
- BAG-1's effects were associated with an activation of RAF-1-a known binding partner of BAG-1, enhanced signaling through the MAP kinase pathway and a decrease in BIM expression. PMID: 19881545
- BAG-1, an anti-apoptotic tumour marker Review PMID: 12049201
- nuclear BAG-1 expression is a useful predictive factor for distant metastasis and a poor prognosis in patients with colorectal cancer. PMID: 12402153
- BAG-1 may function to suppress the GADD34-mediated cellular stress response and have a role in the survival of cells undergoing stress PMID: 12724406
顯示更多
收起更多
-
亞細胞定位:[Isoform 1]: Nucleus. Cytoplasm. Note=Isoform 1 localizes predominantly to the nucleus.; [Isoform 2]: Cytoplasm. Nucleus. Note=Isoform 2 localizes to the cytoplasm and shuttles into the nucleus in response to heat shock.; [Isoform 4]: Cytoplasm. Nucleus. Note=Isoform 4 localizes predominantly to the cytoplasm. The cellular background in which it is expressed can influence whether it resides primarily in the cytoplasm or is also found in the nucleus. In the presence of BCL2, localizes to intracellular membranes (what appears to be the nuclear envelope and perinuclear membranes) as well as punctate cytosolic structures suggestive of mitochondria.
-
組織特異性:Isoform 4 is the most abundantly expressed isoform. It is ubiquitously expressed throughout most tissues, except the liver, colon, breast and uterine myometrium. Isoform 1 is expressed in the ovary and testis. Isoform 4 is expressed in several types of tu
-
數據庫鏈接:
Most popular with customers
-
YWHAB Recombinant Monoclonal Antibody
Applications: ELISA, WB, IHC, IF, FC
Species Reactivity: Human, Mouse, Rat
-
Phospho-YAP1 (S127) Recombinant Monoclonal Antibody
Applications: ELISA, WB, IHC
Species Reactivity: Human
-
-
-
-
-
-